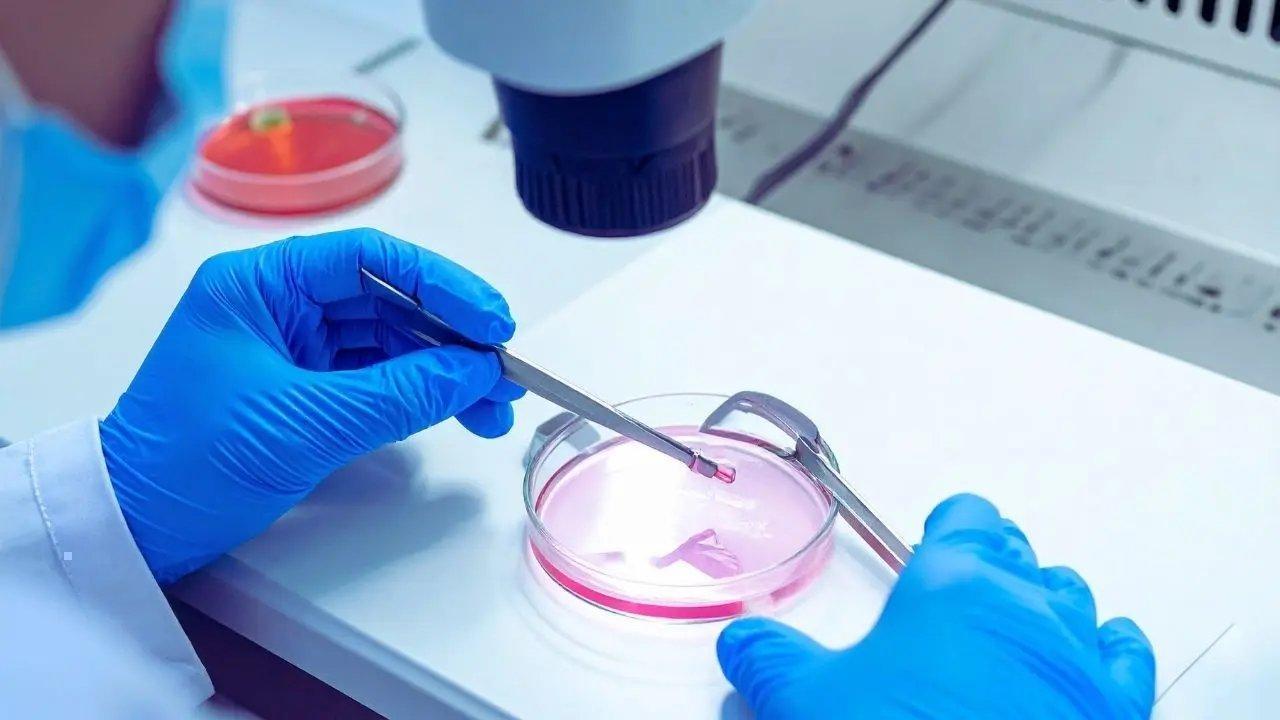
Transformative Biotechnology Advances in 2025: Real Impacts on Health and Agriculture

Post by : Anis Al-Rashid
In 2025, the biotechnology sector has entered one of its most revolutionary phases. Over the previous decade, studies have transitioned from experimental concepts to vital applications affecting patients, farmers, and everyday consumers. This evolution stems from the integration of AI, precision biology, genome editing, and sustainable practices.
Despite some media exaggerations surrounding biotech's potential, numerous real breakthroughs are substantially impacting various fields. From innovative gene therapies targeting previously untreatable conditions to crops designed for challenging climates, the biotechnology landscape is rapidly evolving and stabilizing.
A grasp of ongoing developments in laboratories, clinics, and agricultural settings empowers individuals to appreciate how these advancements influence contemporary society.
In 2025, gene therapy has made significant strides. Therapies once priced in millions and limited to rare diseases are now being adapted for more common conditions. Researchers are crafting targeted treatments that can address defective genes directly, rather than merely alleviating symptoms.
These gene therapies provide renewed hope for those afflicted by:
genetic blood disorders
metabolic conditions
specific types of blindness
certain cancers
Enhanced delivery methods are making these innovations safer, more precise, and accessible to a broader patient audience.
CRISPR genome editing has transcended academic theories and is now being implemented in clinical settings. By 2025, advanced CRISPR technologies—designed to edit genes with heightened accuracy—are ready for patient treatment. This new generation minimizes off-target actions while enhancing effectiveness, setting the stage for direct human applications.
These pioneering efforts have the potential to affect the following:
sickle cell disorders
muscular dystrophy
chronic viral diseases
genetic neurological disorders
Advancements in biotechnology have ushered in a new era for personalized medicine, moving away from generic treatments. Practitioners now harness genetic profiling and tailored therapeutic approaches.
Highlights include:
bespoke cancer treatment strategies
personalized medication dosages
risk evaluations for potential future illnesses
Having dominated recent headlines, mRNA vaccines in 2025 signal an expansive future. Teams of researchers are now effectively leveraging these platforms to design vaccines for:
specific influenza strains
respiratory infections
novel viral threats
rare tropical diseases
The adaptability of mRNA vaccines enables healthcare organizations to swiftly confront evolving pathogens.
In a world struggling with pollution, engineers are harnessing microbes that can efficiently cleanse:
contaminated soil
marine environments
industrial waste regions
Bioremediation presents a natural, less aggressive method of addressing persistent contamination issues.
The noteworthy developments in 2025 confirm that biotechnology has transitioned from theoretical models to a practical agent of change in healthcare and agriculture. Innovations range from individualized medicine to sustainable crops, reinforcing biotech as integral to future progress.
While ethical dilemmas persist, the advantages are undeniable, paving the way for better health, food security, and environmental sustainability. Through understanding both advancements and limitations, society can embrace the future responsibly.
Disclaimer: This article offers insights into biotechnology trends and should not replace professional scientific or medical guidance. Research results can fluctuate based on region, institution, and regulations.










DAE's First Quarter Financial Surge Sets New Highs
Dubai Aerospace Enterprise sees record first-quarter revenue and profit growth, alongside a major ac

Sony's PS5 Price Increase Set for Southeast Asia on May 1
Starting May 1, 2026, Sony will raise PS5 prices across Southeast Asia. Discover what this means for

Potential Super El Niño 2026: Understanding Climate Threats
Is a Super El Niño on the horizon for 2026? Explore its potential effects and global climate implica

Global Oil Supply Crisis Heightens Market Uncertainty | Prices Rise
Global markets are unsettled as oil supply issues escalate, driving prices up and impacting investme

Must-See Attractions in London for Every Traveler
Explore London's top attractions from royal sites to cultural hubs, ensuring an unforgettable trip f

2026 Flight Booking Tips: Secure the Best Rates
Unlock the secrets to finding affordable flights in 2026 with these expert strategies and timing tri